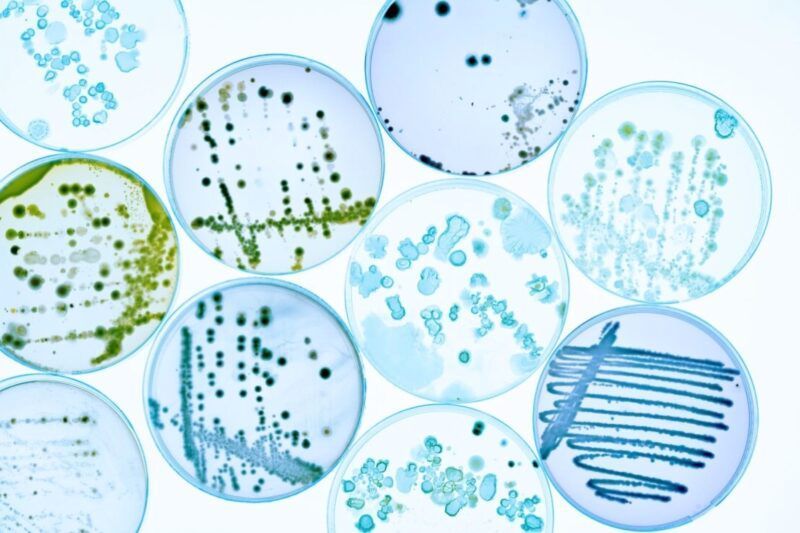

Trockene Haut – Von Papier zu Samt
Trockene Haut juckt, spannt und fühlt sich an wie Papier. Die Trockenheitsfältchen entwickeln sich schnell zu regelrechten Kummerfalten. Doch mit gezielter Hilfe aus der Apotheke muss das nicht so bleiben.
Trockene Haut im Alter: Pflege und Ernährung im Fokus
Mit zunehmendem Alter wird die Haut oft trockener und empfindlicher. Es ist wichtig, unsere tägliche Pflege zu hinterfragen, da auch unsere Ernährung einen massgeblichen Einfluss auf das Hautbild hat. Obwohl das Motto „Forever Young“ mit den besten Pflege- und Ernährungstipps nicht ganz greift, gibt es dennoch effektive Wege, um eine samtene Pfirsichhaut möglichst lange zu erhalten.
«Trockene Haut wird dünner und weniger regenerationsfähig.»
Klimawandel am Körper: Ursachen für Feuchtigkeits- und Elastizitätsverlust der Haut
Der Verlust von Feuchtigkeit und Elastizität der Haut kann viele Ursachen haben. Dazu zählen die feuchtigkeitsarme Heizungsluft im Winter, klimatische Einflüsse wie Kälte, Wind und Sonne sowie aggressive Reinigungsprodukte. Zu häufiges Waschen und irritierende Inhaltsstoffe in Pflegeprodukten—wie Alkohol, ätherische Öle und Duftstoffe — tragen ebenfalls dazu bei. Bereits ab einem Alter von 30 Jahren wird die Haut dünner und trockener, was die Regenerationsfähigkeit verringert und Schäden an der natürlichen Hautbarriere verursachen kann. Dies kann vorzeitige Hautalterung zur Folge haben.
Ihr Hauttyp: So individuell wie Sie
Hauttypen sind so vielfältig wie die Menschen selbst. Zunächst gibt es die unproblematische normale Haut, auf die wir hier nicht näher eingehen. Dann haben wir die „dickere“ fettige Haut, die in Bezug auf Falten einen Vorteil hat, da der glänzende Talgfilm sie schützt und nährt. Mischhaut produziert an Stirn, Nase und Kinn, der sogenannten T-Zone, mehr Talg und neigt wie die fettige Haut zu vergrößerten Poren und Unreinheiten, während die Wangen normal bis trocken sind.
Empfindliche Haut weist viele Gemeinsamkeiten mit trockener Haut auf, da beide häufig zusammen auftreten. Trockene Haut kann ihre Schutzfunktionen nur unzureichend erfüllen, was zu Rötungen, Reizungen, Schuppenbildung und sogar ekzematösen Hautzuständen führen kann.
Sanft und dennoch effizient: Pflege für feuchtigkeitsarme, irritierte Haut
Bei der Pflege von feuchtigkeitsarmer und irritierter Haut bedeutet „sanft“ keineswegs „unwirksam“. Im Gegenteil: Ein auf die individuellen Bedürfnisse abgestimmtes, dermatologisch getestetes und hypoallergenes Pflegeprogramm mit wenigen Inhaltsstoffen ist entscheidend. Die Reinigung sollte milde Tenside (waschaktive Substanzen) enthalten. Dermatologen empfehlen zudem, das Gesicht am besten nur abends zu reinigen.
In unseren Breitengraden ist eine qualitativ hochwertige, feuchtigkeitsspendende und beruhigende Tagespflege in der Regel ausreichend. In den Bergen hingegen ist es sinnvoll, die leichte Tagescreme durch eine reichhaltigere Pflege mit höherem UV-Faktor zu ersetzen, da diese die Haut besser vor Kälte und intensiver Sonneneinstrahlung schützt.
Von innen unterstützen: Der Schlüssel zu schöner Haut
Der Schlüssel zum Glück liegt von innen – das gilt auch für das Thema „Schönheit“. Ausreichend Schlaf und Entspannung sowie genügend stilles Wasser schaffen die Grundlage für ein frisches und erholtes Aussehen. Nahrungsergänzungsmittel, insbesondere Vitamine, Antioxidantien und Mineralstoffe, sowie essenzielle Fettsäuren wie Omega-3, sind wertvolle Unterstützer nicht nur für Ihre Haut, sondern auch für die Gesundheit Ihrer Zellen insgesamt.
Wirkstoffe von Pflegeprodukten im Überblick
Hyaluronsäure
• ist ein effektiver Feuchtigkeitsspender
• ist gut verträglich
• ist eine körpereigene Substanz
Collagen
• ist ein Protein, das die Haut hydratisiert
• spielt eine entscheidende Rolle für die Elastizität der Haut und die Festigkeit des Gewebes
• fördert die Regeneration von Zellen
Ceramide
• sind Lipide, die natürlicherweise in Zellen vorkommen
• unterstützen den Aufbau und Erhalt der Hautbarriere
Urea
• wirkt gegen trockene, schuppende Haut
• hat gute feuchtigkeitsbindende Eigenschaften
Vitamin E
• ist ein starkes Antioxidans
• schützt die Haut vor Umweltschadstoffen